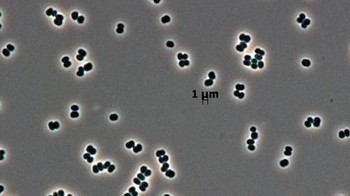
Jumlah mikroba di seluruh dunia bisa mencapai 3.170 octillion (3.170 dengan 27 nol di belakang). (Foto: NASA)

Fakta Unik Bumi dan Alam Semesta yang Mencengangkan

Ternyata, ada lebih dari 500 ribu sampah antariksa di orbit Bumi. NASA memperkirakan masih ada jutaan objek lainnya, tapi ukurannya terlalu kecil. (Foto: NASA)

Sebuah lubang hitam super mampu mengakomodasi satu juta planet yang mengitarinya, dan kesemuanya memungkinkan untuk ditinggali. (Foto: NASA)

Sepanjang hidupnya, pria bisa memproduksi sekitar 525 miliar sperma. Untuk sekali ejakulasi, mereka bisa melepaskan hingga 1,2 juta sel sperma. (Foto: Istimewa)

Ada lebih dari 3 triliun pohon di dunia, tapi tiap tahunnya manusia menebang habis 15 miliar pohon. (Foto: NASA)

Bumi mengandung ribuan triliun ton berlian, tapi letaknya terlalu dalam untuk dijangkau manusia saat ini, yaitu hingga 240 km di bawah permukaan tanah. (Foto: Istimewa)

Seluruh pantai di dunia kira- kira memiliki lebih dari 7 juta triliun (7 dengan 18 nol di belakang) butir pasir. (Foto: NASA)

Masih penasaran lebih banyak butiran pasir atau bintang di langit? Ternyata yang menang adalah bintang karena jumlahnya mencapai 1 septillion (1 dengan 24 nol di belakang). (Foto: NASA)

Peradaban manusia sudah meninggalkan lebih dari 24 sextillion (24 dengan 21 nol di belakang) jejak kaki semenjak eksis di Bumi, dan tentunya angkanya terus bertambah. (Foto: Getty Images)

Jumlah mikroba di seluruh dunia bisa mencapai 3.170 octillion (3.170 dengan 27 nol di belakang). (Foto: NASA)

Butuh 160 nonillion (160 dengan 30 nol di belakang) buah Piramida Agung Giza agar massanya bisa menyamai galaksi Bima Sakti. (Foto: Getty Images)